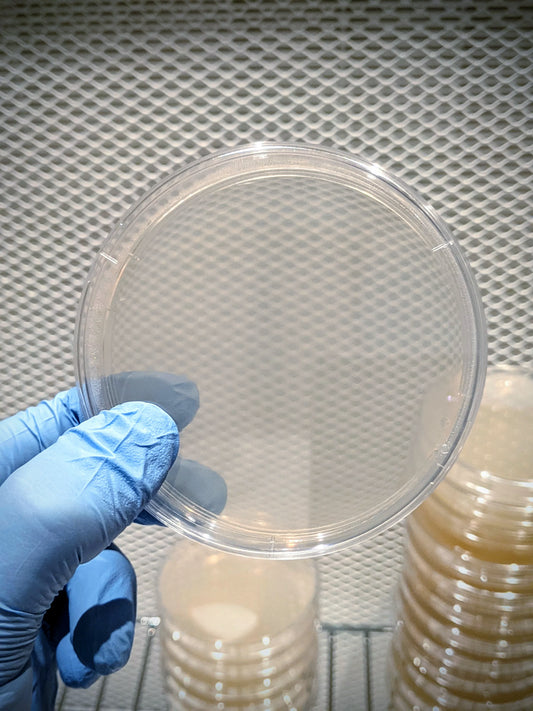

Growers of Mushroom
Masterclass - Autoproduzione Funghi - Livello Base | 1-2 Novembre 2025
Prezzo di listino
€360,00 EUR
Prezzo di listino
€450,00 EUR
Prezzo scontato
€360,00 EUR
Prezzo unitario
per
Imposte incluse.
Spese di spedizione calcolate al check-out.
Visualizza dettagli completi

Kit Blocchi di Coltivazione
-
Kit Blocco di Coltivazione di Funghi - Hericium erinaceus - Lion's mane
Prezzo di listino €26,00 EURPrezzo di listinoPrezzo unitario perPrezzo scontato €26,00 EUR -
Kit Blocco di Coltivazione di Funghi - Pleurotus djamor - Pink Oyster
Prezzo di listino €26,00 EURPrezzo di listinoPrezzo unitario perPrezzo scontato €26,00 EUR -
Kit Blocco di Coltivazione di Funghi - Ganoderma lucidum - Reishi
Prezzo di listino €26,00 EURPrezzo di listinoPrezzo unitario perPrezzo scontato €26,00 EUR -
Kit Blocco di Coltivazione di Funghi - Pleurotus columbinus - Blue Oyster
Prezzo di listino €26,00 EURPrezzo di listinoPrezzo unitario perPrezzo scontato €26,00 EUR
Substrati Sterili
-
Ceres: 1.5kg Avena Idratata Sterilizzata per Grain Spawn
Prezzo di listino Da €15,00 EURPrezzo di listinoPrezzo unitario perPrezzo scontato Da €15,00 EUR -
Starter Kit - Spawn to Bulk!
Prezzo di listino €32,90 EURPrezzo di listinoPrezzo unitario perPrezzo scontato €32,90 EUR -
Iside: 3kg Substrato sterilizzato per la produzione - Base di Fibra di Cocco
Prezzo di listino €24,90 EURPrezzo di listinoPrezzo unitario perPrezzo scontato €24,90 EUR -
Magic Bundle Iside - Ceres: 1.5kg Avena sterilizzata + Iside: 3kg Substrato di Cocco
Prezzo di listino €37,90 EURPrezzo di listinoPrezzo unitario per€41,40 EURPrezzo scontato €37,90 EUR
Articoli Per La Coltivazione
-
5 Buste Coltivazione Funghi Per Substrato/Spawn - Unicorn Bag
Prezzo di listino Da €6,99 EURPrezzo di listinoPrezzo unitario perPrezzo scontato Da €6,99 EUR -
Piastre di Agar Sterili
Prezzo di listino Da €14,90 EURPrezzo di listinoPrezzo unitario perPrezzo scontato Da €14,90 EUR -
Strisce di Parafilm per Sigillare Piastre Petri
Prezzo di listino Da €2,90 EURPrezzo di listinoPrezzo unitario perPrezzo scontato Da €2,90 EUR -
Tappi per Barattoli per Coltura Liquida o Grain Spawn
Prezzo di listino Da €6,90 EURPrezzo di listinoPrezzo unitario perPrezzo scontato Da €6,90 EUR
Micelio
-
Grain Spawn - Micelio Fresco
Prezzo di listino €20,00 EURPrezzo di listinoPrezzo unitario perPrezzo scontato €20,00 EUR -
Liquid Culture - Siringhe di Micelio in Coltura Liquida
Prezzo di listino Da €17,00 EURPrezzo di listinoPrezzo unitario perPrezzo scontato Da €17,00 EUR
Coltivazione su Tronchi
-
Spawn di Segatura - Piopppino
Prezzo di listino €23,00 EURPrezzo di listinoPrezzo unitario perPrezzo scontato €23,00 EUR -
Spawn di Segatura - Blue Oyster
Prezzo di listino €23,00 EURPrezzo di listinoPrezzo unitario perPrezzo scontato €23,00 EUR -
Punta per Inoculazione Tronchi
Prezzo di listino €19,99 EURPrezzo di listinoPrezzo unitario per€23,90 EURPrezzo scontato €19,99 EUR -
Spawn di Segatura -Shiitake
Prezzo di listino €23,00 EURPrezzo di listinoPrezzo unitario perPrezzo scontato €23,00 EUR
Substrati Grezzi
-
Pellet di Segatura di Faggio - Non sterili
Prezzo di listino Da €3,99 EURPrezzo di listinoPrezzo unitario perPrezzo scontato Da €3,99 EUR -
Soy Hulls - Buccette di Soia - Non sterili
Prezzo di listino Da €6,99 EURPrezzo di listinoPrezzo unitario perPrezzo scontato Da €6,99 EUR
Merch
-
Myceliate Society - Growers of Mushroom - T-Shirt
Prezzo di listino €24,99 EURPrezzo di listinoPrezzo unitario perPrezzo scontato €24,99 EUR -
Support Growers of Mushroom Stickers Pack
Prezzo di listino €3,90 EURPrezzo di listinoPrezzo unitario per€4,50 EURPrezzo scontato €3,90 EUR
Let customers speak for us
What customers think about the store
Store specializes in mushroom cultivation products with exceptional customer service. Offers high-quality kits, substrates, and growing supplies. Fast shipping and expert guidance help beginners and experienced growers achieve successful harvests. Professional...
AI-generated from customer reviews.
Instructions Quality Service Shipping